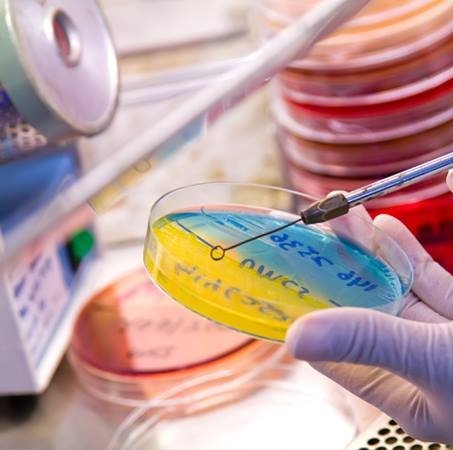

Unidad encargada del correcto ingreso y preparación de las muestras, garantizando su calidad para luego distribuirlas en las diferentes unidades de procesamiento del laboratorio.

En esta unidad se realiza el recuento de elementos celulares, estudio de su morfología y características, además de pruebas de coagulación, entre otros.

Unidad destinada a analizar muestras de sangre y orina con autoanalizadores de alto rendimiento y calidad analítica permitiendo determinar las concentraciones de diferentes analitos presentes en las muestras.
Unidad cuya función principal es la búsqueda e identificación de agentes infecciosos como Bacterias y Hongos, realizar estudios de su sensibilidad a antibióticos aportando información indispensable para el diagnóstico y tratamiento de los pacientes.